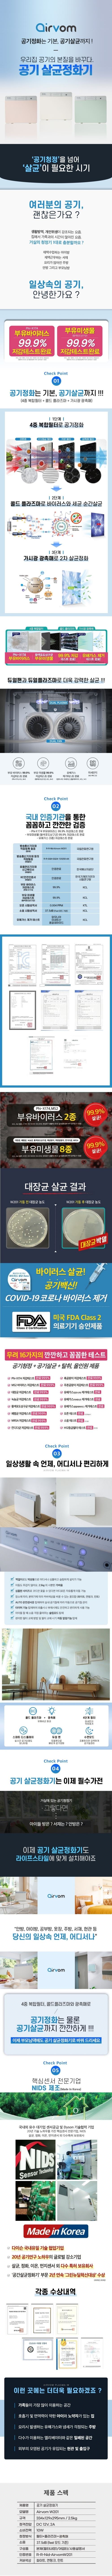

상품 해시태그
(에어봄) 공기 살균청정기(PLASMA W201)/10평형/공기정화/공기살균
결제혜택
INFO신용카드 무이자할부 혜택
| 5만원 이상 결제시 | 무이자 2~3개월 10,12,18,24개월 부분 무이자 |
|
| 5만원 이상 결제시 | 무이자 2~3개월 10,12개월 부분 무이자 |
|
| 5만원 이상 결제시 | 무이자 2~3개월 10,12개월 부분 무이자 |
|
| 5만원 이상 결제시 | 무이자 2~3개월 | |
| 5만원 이상 결제시 | 무이자 2~3개월 6,10,12개월 부분 무이자 |
|
| 5만원 이상 결제시 | 무이자 2~3개월,디지털상품권 제외 | |
| 5만원 이상 결제시 | 무이자 2~8개월 6,10,12개월 부분 무이자 |
|
| 5만원 이상 결제시 | 무이자 2~6개월 10,12개월 부분 무이자 |
|
| 5만원 이상 결제시 | 무이자 2~4개월 10,12개월 부분 무이자 |
|
| 5만원 이상 결제시 | 무이자 2~5개월 6~9개월,10~12개월 부분 무이자 |
|
| 5만원 이상 결제시 | 무이자 2~6개월 |
- 부분무이자 할부는 수수료 고객부담 조건과 이외 추가 조건이 있는지 카드사에 확인 권장
- 사업장(법인,개인), 체크, 선불, 기프트카드는 제외
- 무이자 이용시 포인트/마일리지적립/할인서비스 등 다른혜택과 중복불가
PAYCO
배송비
무료배송
6월 26일 전 도착예정
간격라인
도서산간 배송비 안내
- - 제주 지역5,000원
- - 이외 도서산간 지역5,000원
셀러
실시간 반응
close
moodBuyer Protection
- check 100% 안전과 환불 셀러에 관계없이 상품의 미수령 시 결제대금을 보호 받을 수 있습니다.
- check 구매자 보호프로그램 셀러와 분쟁 시 구매자 보호프로그램을 통해 보호 받을 수 있습니다.
이제 개인판매 걱정 끝! 디비디비가 모든판매의 안전을 보장합니다!
상품정보 제공고시
| 품명 및 모델명 | 상품상세참조 |
| KC 인증 필 유무 | 상품상세참조 |
| 정격전압 | 상품상세참조 |
| 소비전력 | 상품상세참조 |
| 에너지소비효율등급 | 상품상세참조 |
| 동일모델의 출시년월 | 상품상세참조 |
| 제조자(사) | 상품상세참조 |
| 제조국 | 상품상세참조 |
| 크기 | 상품상세참조 |
| 냉난방면적(㎡, ㎠) | 상품상세참조 |
| 추가설치비용 | 상품상세참조 |
| 품질보증기준 | 상품상세참조 |
| A/S 책임자와 전화번호 | 상품상세참조 |
상세설명 접기
상세설명 더보기
상품 문의하기
상품과 배송에 관하여 궁금하신 점이 있으시면
maxplus에 문의해보세요.
고객님의 문의 내용은 셀러만 확인 가능합니다.
문의내역에 대한 답변은 [마이메뉴 > 나의 문의내역]에서 확인해 주세요.
판매자 정보
상품정보 제공고시
배송안내
ㆍ 도서, 산간, 오지, 일부지역, 설치배송 상품 등은 배송비가 추가될 수 있습니다
ㆍ 도서산간 지역 등은 배송에 3~5일이 더 소요될 수 있습니다.
ㆍ 상품의 재고상황이나 배송 상황, 지역에 따라 배송 지연될 수 있으며 이 경우 기입된 정보로 연락을 드립니다.
ㆍ 디지털 상품의 경우 문자 또는 이메일로 발송 됩니다.
ㆍ 도서산간 지역 등은 배송에 3~5일이 더 소요될 수 있습니다.
ㆍ 상품의 재고상황이나 배송 상황, 지역에 따라 배송 지연될 수 있으며 이 경우 기입된 정보로 연락을 드립니다.
ㆍ 디지털 상품의 경우 문자 또는 이메일로 발송 됩니다.
교환 및 반품 안내
ㆍ 상품 수령일로부터 7일 이내 반품, 교환 가능합니다.
ㆍ 단순변심 및 고객님의 사정으로 반품, 교환 하실 경우, 반송비(교환의 경우 왕복배송비)는 고객님 부담입니다.
ㆍ 상품의 내용이 표시·광고의 내용과 다른 경우에는 상품을 수령한 날부터 3개월 이내, 그 사실을 안 날 또는 알 수 있었던 날부터 30일 이내에 청약철회 가능합니다.
ㆍ 디지털 상품의 경우 상품의 속성에 따라 교환 및 반품의 기준이 다를 수 있습니다.
ㆍ 단순변심 및 고객님의 사정으로 반품, 교환 하실 경우, 반송비(교환의 경우 왕복배송비)는 고객님 부담입니다.
ㆍ 상품의 내용이 표시·광고의 내용과 다른 경우에는 상품을 수령한 날부터 3개월 이내, 그 사실을 안 날 또는 알 수 있었던 날부터 30일 이내에 청약철회 가능합니다.
ㆍ 디지털 상품의 경우 상품의 속성에 따라 교환 및 반품의 기준이 다를 수 있습니다.
교환 및 반품 제한사항
* 아래와 같은 경우 상품의 교환 및 반품에 제한이 있을 수 있습니다.
ㆍ 주문/제작 상품의 경우, 상품의 제작이 이미 진행된 경우
ㆍ 상품 및 구성품을 분실 하였거나 취급부주의로 인한 파손, 고장, 오염이 된 경우
ㆍ 상품사용 또는 구성품을 사용, 소비하였을 경우
ㆍ 모니터 해상도의 차이로 인해 색상이나 이미지가 실제와 달라 고객이 단순 변심으로 교환/반품을 무료로 요청하는 경우
ㆍ 교환, 반품신청을 하였으나 고객님의 귀책 사유로 인해 수거가 지연될 경우
ㆍ 제조사의 사정(신모델 출시 등) 및 부품 가격 변동 등에 의해 무료 교환/반품으로 요청하는 경우
* 각 상품별로 아래와 같은 사유로 취소/반품이 제한 될 수 있습니다.
ㆍ 의류/잡화/수입명품
- 상품의 택(TAG) 제거, 라벨 및 상품 훼손, 구성품 누락으로 상품의 가치가 현저히 감소된 경우
ㆍ 계절상품/식품/화장품
- 신선냉동 식품의 단순변심의 경우
- 뷰티 상품 이용 시 트러블(알러지, 붉은 반점, 가려움, 따가움)이 발생하는 경우, 진료 확인서 및 소견서 등을 증빙하면 환불이 가능 (제반비용 고객부담)
ㆍ 전자/가전/설치상품
- 전자제품의 특성 상 본품 박스를 개봉한 경우
- 설치 또는 사용하여 재판매가 어려운 경우, 액정이 있는 상품의 전원을 켠 경우
- 상품의 시리얼 넘버 유출로 내장된 소프트웨어의 가치가 감소한 경우 (내비게이션, OS시리얼이 적힌 PMP)
- 홀로그램 등을 분리, 분실, 훼손하여 상품의 가치가 현저히 감소하여 재판매가 불가할 경우 (노트북, 데스크탑 PC 등)
ㆍ 자동차용품
- 상품을 개봉하여 장착한 이후 단순변심인 경우
ㆍ CD/DVD/GAME/BOOK
- 복제가 가능한 상품의 포장 등을 훼손한 경우
ㆍ 주문/제작 상품의 경우, 상품의 제작이 이미 진행된 경우
ㆍ 상품 및 구성품을 분실 하였거나 취급부주의로 인한 파손, 고장, 오염이 된 경우
ㆍ 상품사용 또는 구성품을 사용, 소비하였을 경우
ㆍ 모니터 해상도의 차이로 인해 색상이나 이미지가 실제와 달라 고객이 단순 변심으로 교환/반품을 무료로 요청하는 경우
ㆍ 교환, 반품신청을 하였으나 고객님의 귀책 사유로 인해 수거가 지연될 경우
ㆍ 제조사의 사정(신모델 출시 등) 및 부품 가격 변동 등에 의해 무료 교환/반품으로 요청하는 경우
* 각 상품별로 아래와 같은 사유로 취소/반품이 제한 될 수 있습니다.
ㆍ 의류/잡화/수입명품
- 상품의 택(TAG) 제거, 라벨 및 상품 훼손, 구성품 누락으로 상품의 가치가 현저히 감소된 경우
ㆍ 계절상품/식품/화장품
- 신선냉동 식품의 단순변심의 경우
- 뷰티 상품 이용 시 트러블(알러지, 붉은 반점, 가려움, 따가움)이 발생하는 경우, 진료 확인서 및 소견서 등을 증빙하면 환불이 가능 (제반비용 고객부담)
ㆍ 전자/가전/설치상품
- 전자제품의 특성 상 본품 박스를 개봉한 경우
- 설치 또는 사용하여 재판매가 어려운 경우, 액정이 있는 상품의 전원을 켠 경우
- 상품의 시리얼 넘버 유출로 내장된 소프트웨어의 가치가 감소한 경우 (내비게이션, OS시리얼이 적힌 PMP)
- 홀로그램 등을 분리, 분실, 훼손하여 상품의 가치가 현저히 감소하여 재판매가 불가할 경우 (노트북, 데스크탑 PC 등)
ㆍ 자동차용품
- 상품을 개봉하여 장착한 이후 단순변심인 경우
ㆍ CD/DVD/GAME/BOOK
- 복제가 가능한 상품의 포장 등을 훼손한 경우
환불안내
ㆍ 상품불량 및 오배송 등의 이유로 반품, 교환 하실 경우, 반품 배송비는 무료입니다.
ㆍ 반품, 교환을 원하시는 경우 1:1문의나 주문서에 안내 해 드리고 있는 연락처로 연락 주시면 신속한 처리가 가능합니다.
ㆍ 수령일로부터 7일 이내 반품, 교환 가능합니다.
ㆍ 판매자가 반품상품 확인 후 상품불량이 아닌 것으로 판명 시 반송비(또는 왕복배송비)를 고객님께 부과할 수 있습니다.
ㆍ 무료배송 상품이라도 반품 시 최초 배송료를 포함한 왕복 배송비가 부과될 수 있습니다.
ㆍ 아래의 경우 반품 또는 교환이 불가할 수 있습니다.
- 제품 수령일 기준으로 7일을 초과하였을 경우
- 상품 및 구성품을 분실 하였거나 취급부주의로 인한 파손, 고장, 오염이 된 경우
- 상품사용 또는 구성품을 사용, 소비하였을 경우
- 교환, 반품신청을 하였으나 고객님의 귀책 사유로 인해 수거가 지연될 경우
- 일부 상품의 경우 예고없이 가격변동이 될 수 있으며 이로인한 반품 및 가격보상은 불가
- 상품택(Tag), 홀로그램, 상품에 대한 정보물 일체 등이 분리, 분실, 훼손되어 상품의 가치가 현저히 감소하여 재판매가 불가능하다고 판단되는 경우
- 일부 전자상품의 경우 박스를 개봉한 경우 환불불가
ㆍ 그 외 전자상거래등에서의 소비자보호에 관한 법률이 정하는 청약철회 제한에 해당하는 경우
ㆍ 반품, 교환을 원하시는 경우 1:1문의나 주문서에 안내 해 드리고 있는 연락처로 연락 주시면 신속한 처리가 가능합니다.
ㆍ 수령일로부터 7일 이내 반품, 교환 가능합니다.
ㆍ 판매자가 반품상품 확인 후 상품불량이 아닌 것으로 판명 시 반송비(또는 왕복배송비)를 고객님께 부과할 수 있습니다.
ㆍ 무료배송 상품이라도 반품 시 최초 배송료를 포함한 왕복 배송비가 부과될 수 있습니다.
ㆍ 아래의 경우 반품 또는 교환이 불가할 수 있습니다.
- 제품 수령일 기준으로 7일을 초과하였을 경우
- 상품 및 구성품을 분실 하였거나 취급부주의로 인한 파손, 고장, 오염이 된 경우
- 상품사용 또는 구성품을 사용, 소비하였을 경우
- 교환, 반품신청을 하였으나 고객님의 귀책 사유로 인해 수거가 지연될 경우
- 일부 상품의 경우 예고없이 가격변동이 될 수 있으며 이로인한 반품 및 가격보상은 불가
- 상품택(Tag), 홀로그램, 상품에 대한 정보물 일체 등이 분리, 분실, 훼손되어 상품의 가치가 현저히 감소하여 재판매가 불가능하다고 판단되는 경우
- 일부 전자상품의 경우 박스를 개봉한 경우 환불불가
ㆍ 그 외 전자상거래등에서의 소비자보호에 관한 법률이 정하는 청약철회 제한에 해당하는 경우
참고사항
ㆍ 전자상거래 등에서의 소비자 보호에 관한 법률에 의한 반품규정이 판매자가 지정한 반품조건보다 우선합니다.
ㆍ 구매자가 미성년자인 경우에는 상품 구입시 법정 대리인이 동의하지 아니하면 미성년자 본인 또는 법정 대리인이 구매취소 할 수 있습니다.
ㆍ 사용 중 발생한 하자의 환불/교환/수리 등은 공정거래위원회 소비자분쟁해결기준에 준하여 처리됩니다. (제조사/브랜드 A/S센터로 문의)
ㆍ 대금 환불 및 환불 지연에 따른 배상금 지급 조건, 절차 등은 전자상거래 등에서의 소비자 보호에 관한 법률에 따라 처리합니다.
ㆍ 전기용품안전관리법 및 전기통신기본법, 전파법에 의거하여 인증 대상 상품을 구매하실 경우, 안전인증 또는 형식승인, 전자파적합등록 제품 여부를 확인하시기 바랍니다.
ㆍ 반품/교환 시 고객님 귀책사유로 인해 수거가 지연될 경우에는 반품이 제한될 수 있습니다.
ㆍ 구매자가 미성년자인 경우에는 상품 구입시 법정 대리인이 동의하지 아니하면 미성년자 본인 또는 법정 대리인이 구매취소 할 수 있습니다.
ㆍ 사용 중 발생한 하자의 환불/교환/수리 등은 공정거래위원회 소비자분쟁해결기준에 준하여 처리됩니다. (제조사/브랜드 A/S센터로 문의)
ㆍ 대금 환불 및 환불 지연에 따른 배상금 지급 조건, 절차 등은 전자상거래 등에서의 소비자 보호에 관한 법률에 따라 처리합니다.
ㆍ 전기용품안전관리법 및 전기통신기본법, 전파법에 의거하여 인증 대상 상품을 구매하실 경우, 안전인증 또는 형식승인, 전자파적합등록 제품 여부를 확인하시기 바랍니다.
ㆍ 반품/교환 시 고객님 귀책사유로 인해 수거가 지연될 경우에는 반품이 제한될 수 있습니다.
AS안내
ㆍ 소비자분쟁해결 기준(공정거래위원회 고시)에 따라 피해를 보상받을 수 있습니다.
ㆍ 제품의 초기불량에 해당하는 경우 환불, 교환, A/S를 받으실 수 있습니다.
ㆍ 제품의 불량이 아닌 소비자의 귀책사유로 제품의 불량이 발생한 경우에는 환불, 교환을 받으실 수 없습니다.
ㆍ 자세한 A/S 문의는 판매자 또는 제품 제조회사에 문의 바랍니다.
ㆍ 제품의 초기불량에 해당하는 경우 환불, 교환, A/S를 받으실 수 있습니다.
ㆍ 제품의 불량이 아닌 소비자의 귀책사유로 제품의 불량이 발생한 경우에는 환불, 교환을 받으실 수 없습니다.
ㆍ 자세한 A/S 문의는 판매자 또는 제품 제조회사에 문의 바랍니다.

디비디비 신춘문예 리뷰만 봐도 구매각!